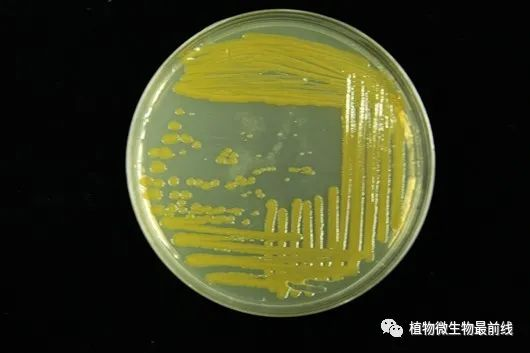

冰川中蕴藏着黄杆菌 周宇光供图

研究涉及的40余株黄杆菌采集地 图片来源:东秀珠等
近日,中科院微生物研究所东秀珠、周宇光研究组通过对采集自西藏、新疆、甘肃、四川等地的冰川黄杆菌菌株的研究,发现一种类胡萝卜素——玉米黄质有助于它们在低氧低营养条件下利用光能生长,这一新发现对国际上一直以来普遍认为的视紫红质决定黄杆菌的光促生长机制提出了挑战。相关成果近日发表于《国际微生物生态学会会刊》。

“这将扩大我们对微生物利用光作为能源手段的理解,也有助于解释人们经常观察到的一个现象,即从冰川分离出来的许多微生物多产生色素。”该刊审稿人如是评价这一潜在的新光能利用机制。
打破现有结论
光合作用是地球生物赖以生存的基础。色素是光合作用捕捉太阳光能量的“器官”。植物、藻类和一些细菌通过叶绿素转化光能为生物能,并将水、二氧化碳、氮化物等转化为淀粉、脂肪、蛋白质和核酸等有机物。
地球上已知的光营养代谢所依赖的色素主要有三大类:叶绿素、类胡萝卜素和藻胆素。
一直以来,国际上普遍认为变形菌视紫红质是黄杆菌的利用光能的功能蛋白。
视紫红质是一种膜结合蛋白,它本身不能感光,而是需要结合视黄醛分子(一种类胡萝卜素)接受光能。“视黄醛其实就是维生素A的类似物。”论文通讯作者、微生物所研究员东秀珠在接受《中国科学报》采访时说。
冰川黄杆菌 周宇光供图
在东秀珠的带领下,研究人员对采集自西藏、新疆、甘肃、四川等地冰川的47株冰川黄杆菌进行了多组学研究。基因组分析发现其中37株含有变形菌视紫红质基因,另外10株不含该基因。然而,光照生长实验发现无论是携带、无视紫红质基因的黄杆菌,还是人工敲除该基因的菌株均表现出光促生长的特性。
“从这些研究菌株的基因表达谱看,视黄醛合成基因几乎不表达;也未检测这些菌株中合成视黄醛。所以,我们认为光促生长应与视紫红质无关。”东秀珠说。
这项研究无疑对一直以来的观点形成了挑战。
玉米黄质或促细菌光生长
大约20年前,研究人员在海洋中发现黄杆菌携带利用光能产生质子泵的视紫红质蛋白,并赋予黄杆菌利用光能适应低营养环境。
“如果说(黄杆菌的生长)跟视紫红质没关系,那么在低氧、寡营养的冰川条件下,它到底跟什么有关系呢?”东秀珠与合作者继续追问。
进一步研究,他们发现冰川黄杆菌的光促生长与玉米黄质等色素合成相关。玉米黄质、番茄红素等β类胡萝卜素可以为冰川黄杆菌提供光辐射保护、维持低温下细胞膜稳定性等作用,而仅含有黄色素的冰川黄杆菌无法在光照条件下生长。

冰川黄杆菌含有玉米黄质、番茄红素等β类胡萝卜素 图片来源:东秀珠等
“作者报道了光刺激冰川黄杆菌生长,产生玉米黄质。作者通过生理实验、基因组和转录组分析,发现了一种类似于冰川黄杆菌的变形视紫红质光能采集系统的新机制。”文章审稿人、中科院青藏高原所研究员刘勇勤评价,“这个话题很有趣,结果也很有说服力。”
“如果这一模型成立,它将是另一种新的光能利用机制(或者至少是光介导的能量守恒)。”该研究另一位审稿人称。该审稿人期待未来能够进一步厘清玉米黄质的光促机制。
打造微生物资源“银行”
冰川一直是极端微生物学研究领域的热点环境,其中蕴藏着丰富的低温微生物,冰川生态环境赋予了冰川微生物物种、遗传和代谢的多样性。以玉米黄质为例,东秀珠介绍,这是一种带有极性的类胡萝卜素。“与我们吃的胡萝卜、西红柿里的类胡萝卜素类似,具有脂溶性,用油炒比直接食用更容易吸收。”她补充说。
低温菌的细胞膜多由不饱和的脂肪酸组成,流动性强,可保证细胞膜在低温下不凝固,与外界进行物质交流。但不饱和的脂肪酸组成的细胞膜也容易破裂。玉米黄质这种带有极性的类胡萝卜素就像一个骨架,分子骨架部分嵌入细胞膜内部、而头部位于膜的外部,加强了细胞膜在低温下整体结构、不容易破裂。
作为国内第一个通过国际标准ISO9001认证的保藏中心,中国微生物菌种保藏管理委员会普通微生物中心(CGMCC)主任、微生物所菌种保藏中心主任周宇光介绍,目前CGMCC承担保藏的三类菌种——普通微生物菌种、基础研究菌种、病原微生物菌毒种,菌种资源总量超过8万株,包括分离自我国11条冰川的低温细菌菌种4000余株,建立了我国特色的冰川低温细菌菌种资源库。
冰川微生物是发现新材料、新基因、新机制和新功能的理想资源。我国南北温度差异大,将高-中-低温菌用于温度适应的地区,会对工农业生产带来巨大的便利。如一些低温酶可提高北方寒冷地区洗涤剂的除菌去污能力,一些低温菌也有利于冬季北方地区沼气发酵、东北地区黑土地生物降解再利用等。周宇光举例说。
“正是因为8年前我们很好地保藏了这些黄杆菌,才有今天的这项研究结果。”东秀珠说。
保藏中心就像一个微生物“银行”,将科研中积累的微生物资源收集保存,并提供给研究者深入研究生物学特征、代谢途径及其基因功能。“在保藏的基础上共享,实现微生物资源的可持续利用,这样国家的前期投入可为后续研究奠定基础,这也是国家成立这样非营利性的公益平台的原因。”周宇光说。
相关论文信息:
https://doi.org/10.1038/s41396-020-00891-w
来源:中国科学报
猜你喜欢
10000+:菌群分析 宝宝与猫狗 梅毒狂想曲 提DNA发Nature Cell专刊 肠道指挥大脑
文献阅读 热心肠 SemanticScholar Geenmedical
16S功能预测 PICRUSt FAPROTAX Bugbase Tax4Fun
生物科普: 肠道细菌 人体上的生命 生命大跃进 细胞暗战 人体奥秘
写在后面
为鼓励读者交流、快速解决科研困难,我们建立了“宏基因组”专业讨论群,目前己有国内外5000+ 一线科研人员加入。参与讨论,获得专业解答,欢迎分享此文至朋友圈,并扫码加主编好友带你入群,务必备注“姓名-单位-研究方向-职称/年级”。PI请明示身份,另有海内外微生物相关PI群供大佬合作交流。技术问题寻求帮助,首先阅读《如何优雅的提问》学习解决问题思路,仍未解决群内讨论,问题不私聊,帮助同行。

学习16S扩增子、宏基因组科研思路和分析实战,关注“宏基因组”
 点击阅读原文,跳转最新文章目录阅读
点击阅读原文,跳转最新文章目录阅读
























 被折叠的 条评论
为什么被折叠?
被折叠的 条评论
为什么被折叠?








